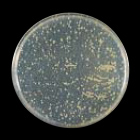
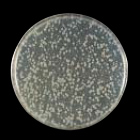
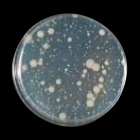

安全・衛生管理対策
衛生管理対策
塗り床 長尺シート 食品工場のHACCP導入をサポート
HACCP International社とは、食品以外の汚染源となり得る機器・材料・サービス等が、食品安全の見地から見て適切であるかどうかを認証する第三者機関です。下記商品は、HACCP International社認証マークを取得し、清掃・洗浄がしやすい床材として、食品製造工場の衛生管理に貢献します。
認証マーク
ウェットシステム向け
水や熱水を頻繁に流し床の勾配によって排水する厨房に
[条件]熱水に耐えられる床材を選定

カリタス小学校
タフクリートSD SD工法 #2611/タフクリートMW #2455
ドライシステム向け
床を濡らしても水を掻きとり乾燥状態を維持する厨房に
[条件]細菌の繁殖抑制のため、水はけや清掃性の良い床材を選定

伊勢崎市第一学校給食調理場
アルトロセーフティーフロア D-25332/D-25905
上記対応建材
-
長尺シート
腰壁保護シート 塗り床 国際基準のSIAA抗菌加工認証製品
腰壁保護シート・ハイデックスユーゴ抗菌、樹脂系塗り床材・ルメアコートトップMR、ビューコートMRは、SIAAマーク取得。
細菌の増殖を抑制し、衛生管理に貢献します。
SIAAマーク
SIAAマークはISO22196法により評価された結果に基づき、抗菌製品技術協議会ガイドラインで品質管理・情報公開された製品に表示されています。
※塗料はSIAA規定によりISO22196の表示がないマークとなります。
一般社団法人 抗菌製品技術協議会 WEBサイト
写真はハイデックスユーゴです
写真はビューコートです
抗菌試験
ハイデックスユーゴ抗菌
| 試験菌 | 前処理 | 抗菌活性値 |
|---|---|---|
| 黄色ぶどう球菌 | 耐水 | 3.6 |
| 耐光 | 3.4 | |
| 大腸菌 | 耐水 | 3.6 |
| 耐光 | 2.7 |
- ●試験方法:JIS Z 2801(2010年)「抗菌加工製品ー抗菌性試験方法・抗菌効果」試験方法に準ずる。
- ●前処理方法:抗菌加工製品の抗菌力持続性試験法(抗菌製品技術協議会 試験法):JNLA登録区分外
- ●耐水性試験:区分1(常温×16時間)
- ●耐光性試験:区分1(キセノン(60W/m2)・10時間)
- ※抗菌効果:抗菌活性値2.0以上
ルメアコートトップMR
| 試験菌 | 前処理 | 抗菌活性値 |
|---|---|---|
| 黄色ぶどう球菌 | 耐水 | 2.0以上 |
| 耐光 | 2.0以上 | |
| 大腸菌 | 耐水 | 2.0以上 |
| 耐光 | 2.0以上 |
- ●耐水処理:区分2
- ●耐光処理:区分1
- ※抗菌効果:抗菌活性値2.0以上
ビューコートMR
| 試験菌 | 前処理 | 抗菌活性値 |
|---|---|---|
| 黄色ぶどう球菌 | 耐水 | 2.0以上 |
| 耐光 | 2.0以上 | |
| 大腸菌 | 耐水 | 2.0以上 |
| 耐光 | 2.0以上 |
- ●耐水処理:区分2
- ●耐光処理:区分1
- ※抗菌効果:抗菌活性値2.0以上
上記対応建材
-
腰壁保護シート
-
塗り床材
長尺シート 人工大理石 消毒液の影響を受けにくい素材
アンビアンスは、衛生的な環境が求められる施設におすすめです。表面のEvercare™(UVコーティング)によりこぼれ落ちる消毒用エタノールなど、薬品による劣化を抑制します。また、すぐれた抗菌効果により食中毒を引き起こす原因となる細菌の増殖を抑制します。
埼玉石心会病院
アンビアンスへの消毒剤の検証結果
| 試薬 | 結果(※) |
|---|---|
| 消毒用エタノール80% | 異常なし |
- ※試薬2ml滴下、24時間後目視観察
アンビアンスへの抗菌試験
※表をスワイプして閲覧ください
| 菌種 | 開始時 | 24時間後 | 抗菌活性値 (2.0以上で抗菌性あり) |
|---|---|---|---|
| 黄色 ぶどう球菌 |
![]() |
![]() |
>6.1 |
| 大腸菌 | ![]() |
![]() |
>4.7 |
- ●JIS Z 2801(2012年)「抗菌加工製品-抗菌性試験方法・抗菌効果」5 試験方法に準ずる。
- ●試験場所:(一財)日本食品分析センター
- ※試験結果は試験値で保証値ではありません。
- ※試験結果は特定のウイルス・菌を対象としたものであり、すべてのウイルス・菌への効果を示すものではありません。
- ※本製品は病気の治療や予防を目的としたものではありません。また、ウイルス自体を分解・忌避するものではありません。
コーリアン®は架橋構造を持つ樹脂成分で構成されているため一般的なアクリルよりアルコール消毒による破損や変色に強い素材です。
東京湾アクアライン 海ほたるパーキングエリア
コーリアン®への消毒剤の検証結果
※表をスワイプして閲覧ください
| 一般名 | コーリアン®で 検証した商品名 |
コーリアン®への影響 | 洗浄方法 |
|---|---|---|---|
| グルタルアルデヒド (グルタラール) |
ステリハイドL(10倍希釈) | なし | 水拭き |
| 次亜塩素酸ナトリウム | ピューラックス(原液) | なし | 水拭き |
| ポピドンヨード | イソジン(原液) | 若干の色付き | ※1 |
| 消毒用エタノール | 70%エタノール | なし(※3) | 自然乾燥または水拭き(※3) |
| クレゾール石鹸 | フェノール5% | 若干のツヤ消し | ※2 |
| 塩化ベンザルコニウム (逆性石鹸) |
オスバン(原液) | なし | 水拭き |
| クロルヘキシジン | ヒビテン液(原液) | なし | 水拭き |
評価方法:社内法(カメオホワイト使用:23℃で24時間放置)
- ※1
水を含ませたメラミンスポンジまたはスコッチ・ブライト™(研磨粒子付)で弧を描くように磨く。
- ※2
水を含ませたスコッチ・ブライト™(研磨粒子付)またはクリームクレンザー処理。
- ※3
アルコール使用時の注意点。
- ●アルコールは揮発性のため、通常使用ではコーリアン®に影響はありません。しかし、アルコールが揮発できない状況(例えば、アルコールをスプレーした直後に物を上から置くなど)を作った場合、天板の表面が若干荒れてしまう場合がありますので十分ご注意ください。
- ●濃色系コーリアン®の場合、アルコールを噴霧し、自然乾燥させると光沢斑が出る場合がありますので、ペーパータオル等にアルコールを含ませて拭いてください。その後アルコールが揮発したことをご確認ください。適切にご使用いただくことで、濃色のコーリアン®においてもアルコールをご使用いただけます。
人工大理石 ウイルスや細菌が入り込みにくい素材
コーリアン®はウイルスや細菌が入り込みにくい素材のため、天板などにおすすめです。
下の写真は、コーリアン®の表面を電子顕微鏡で撮影した画像です。
素材自体に隙間がなく、孔は見えません。
このため、ウイルスや細菌、カビや汚れが素材にとどまりづらく、日常の簡単な拭き掃除によって清潔に保つことができます。
公衆安全衛生分野の国際機関が認証する「NSF」を取得しています。
電子顕微鏡(150倍)で撮影
NSFマーク
アメリカ規格協会(ANSI)、カナダ審議会(SCC)などに認定されている世界標準の認証システムです。公共の健康と安全性、環境保護に取り組む認証で、製造施設の現場検査、製品の検査を定期的に行ない、継続的に品質を保証しています。
朝倉病院 本館
スタンダードカウンター(カウンタートップ) セピアリニア(廃番色)
お問い合わせ
お気軽にお問い合わせください